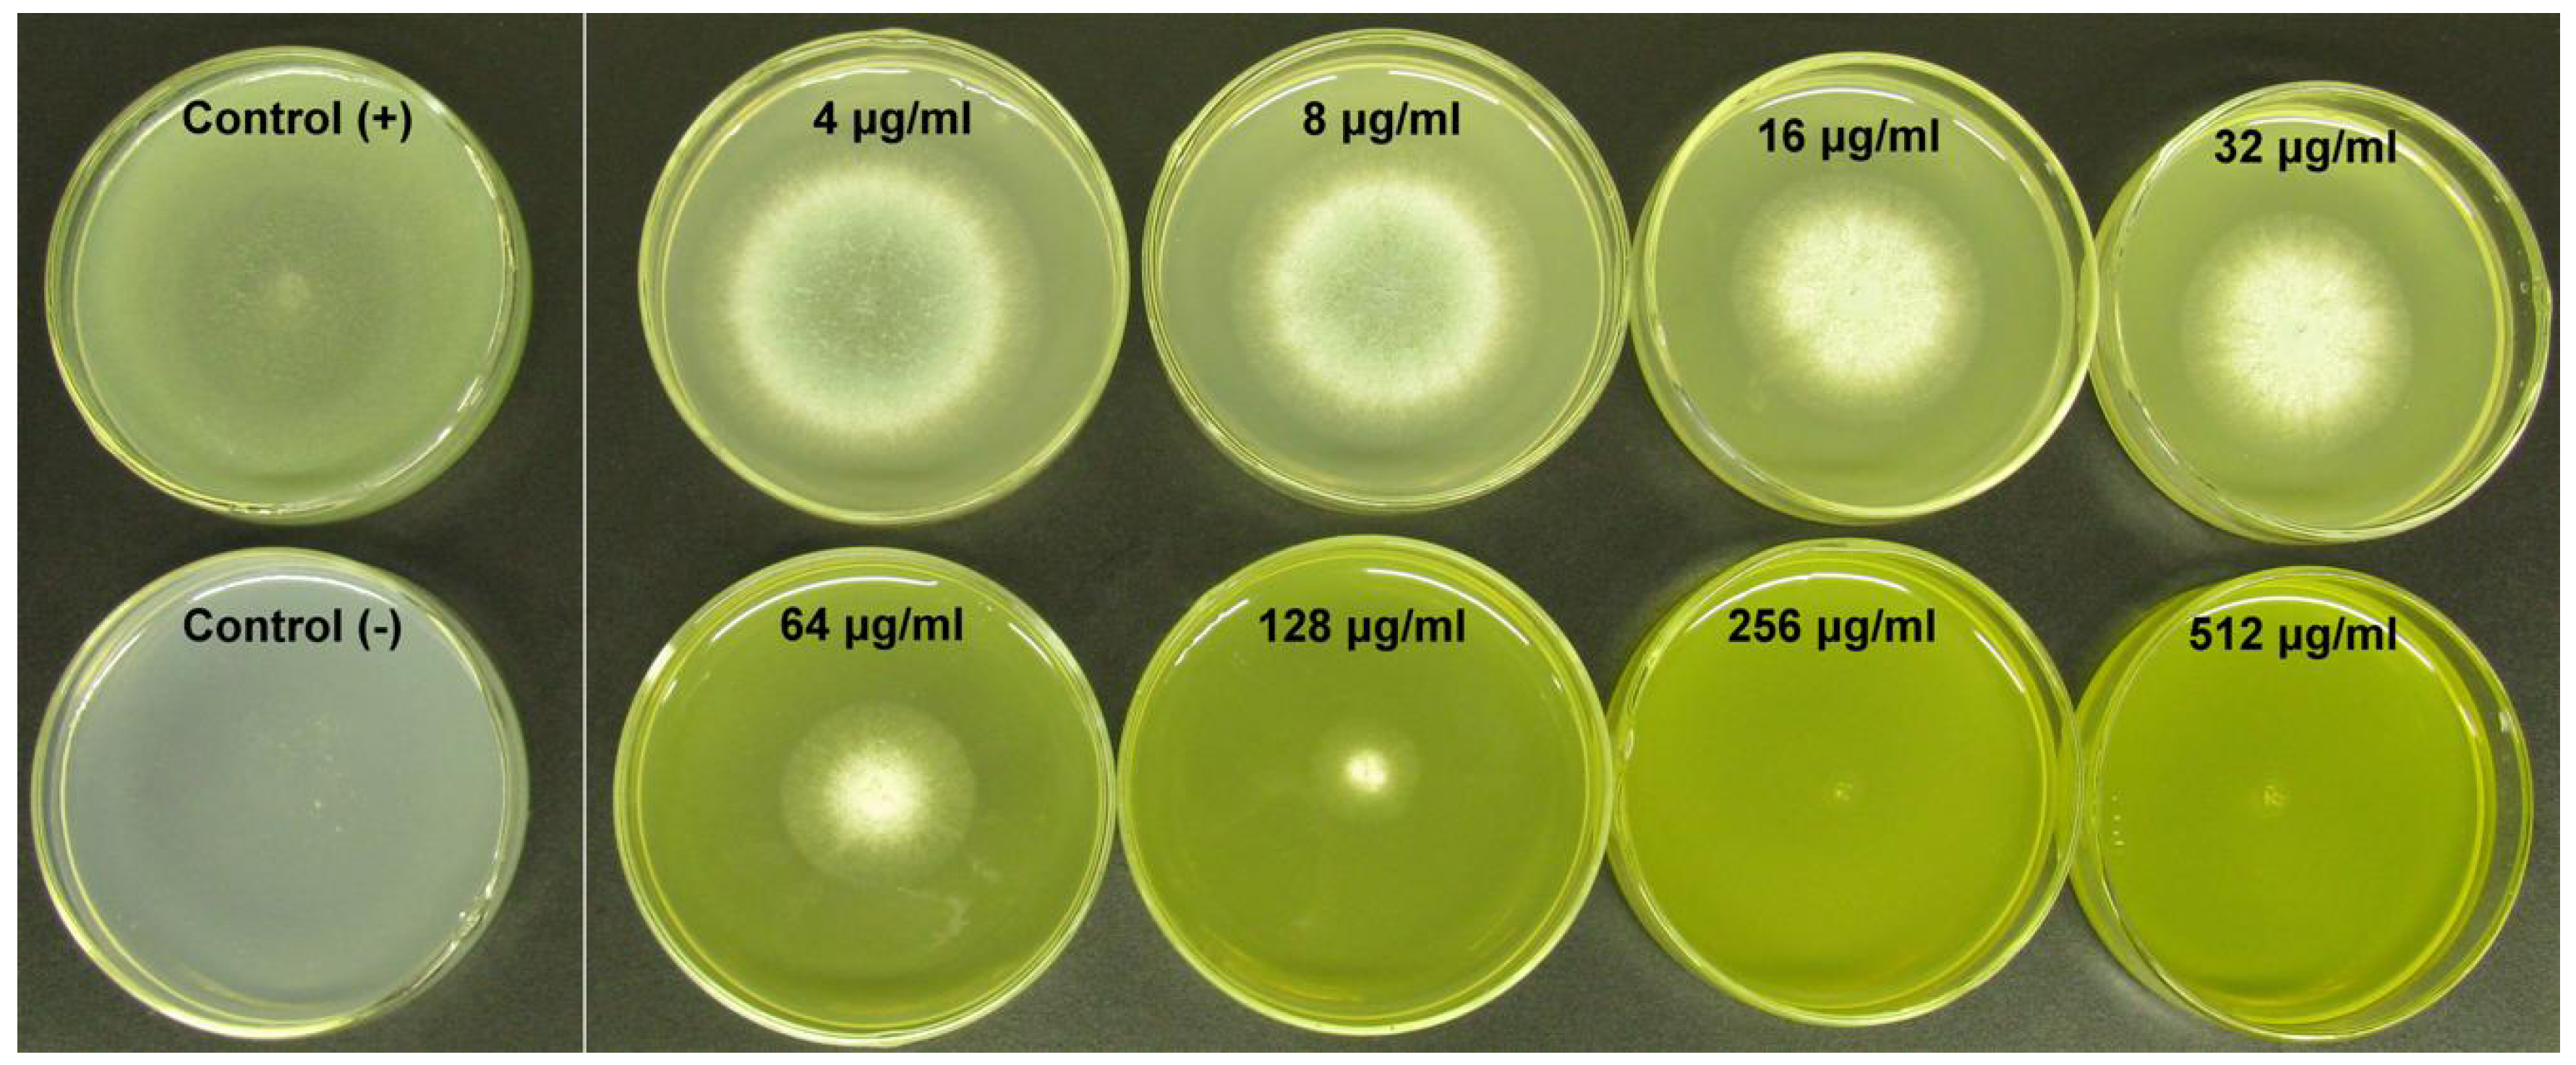
Molecules 16 09218 g003
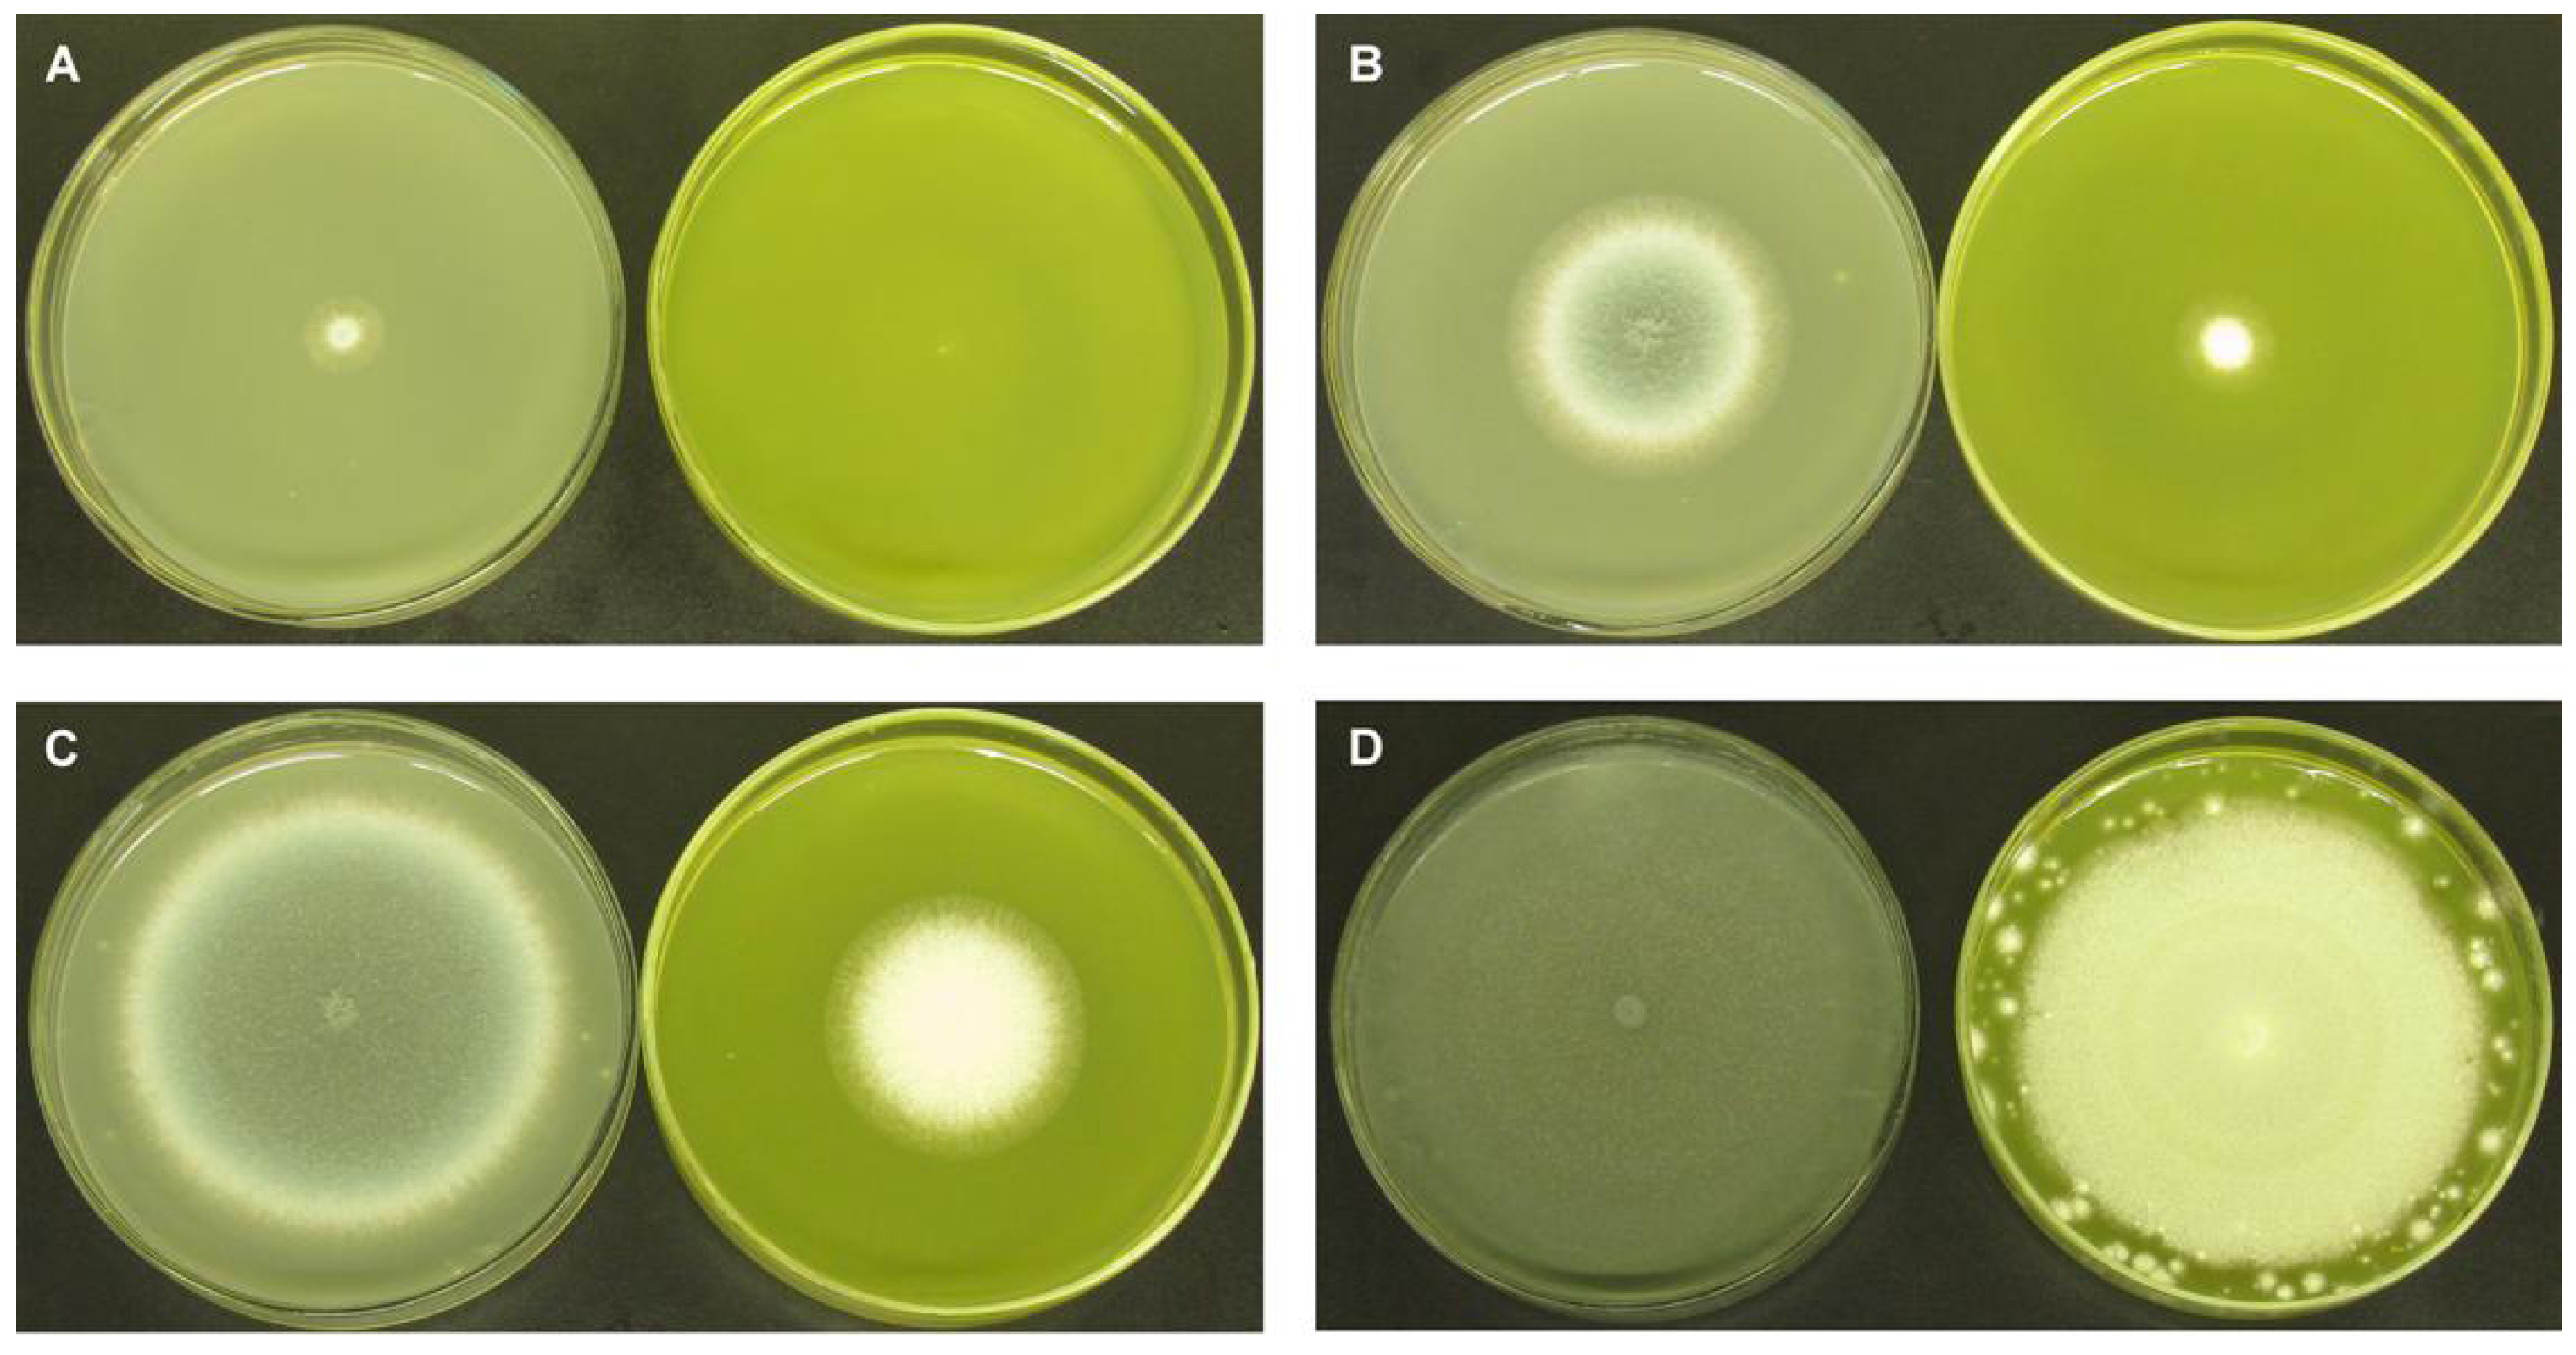
Molecules 16 09218 g004

Berberine and Itraconazole Are not Synergistic in Vitro against Aspergillus fumigatus Isolated from Clinical Patients
Abstract
:1. Introduction


2. Results and Discussion
2.1. Results
2.1.1. Influence of BER and ICZ on A. fumigatus
| Strain No. | MIC50 (μg/mL) | FICI | |
|---|---|---|---|
| BER | ICZ | ||
| IFM 40808 | 8 | 0.125 | 4.5 |
| JLCC 30436 | 256 | 0.250 | 3.7 |
| JLCC 30468 | 8 | 0.031 | 5.5 |
| JLCC 30470 | 8 | 0.031 | 8.0 |
| JLCC 30482 | 32 | 0.063 | 3.5 |
| JLCC 30490 | 8 | 0.031 | 4.2 |
| JLCC 30506 | 32 | 0.063 | 4.7 |
| JLCC 30507 | 32 | 0.063 | 3.9 |
| JLCC 30540 | 8 | 0.031 | 6.8 |
| JLCC 30541 | 4 | 0.031 | 7.0 |
| JLCC 30542 | 4 | 0.063 | 5.0 |
| JLCC 30545 | 128 | 0.125 | 2.9 |
| JLCC 30653 | 16 | 0.063 | 5.5 |
| JLCC 30654 | 8 | 0.063 | 2.5 |
| JLCC 30685 | 128 | 0.125 | 7.5 |
| JLCC 30717 | 8 | 0.031 | 6.9 |
| JLCC 30753 | 8 | 0.031 | 5.5 |
| JLCC 30782 | 4 | 0.031 | 8.0 |
| JLCC 30796 | 16 | 0.063 | 4.8 |
| JLCC 30854 | 8 | 0.031 | 3.0 |
| JLCC 30858 | 256 | 0.250 | 4.1 |
| JLCC 30859 | 256 | 0.250 | 3.5 |
| JLCC 30860 | 4 | 0.031 | 5.0 |
| JLCC 30883 | 128 | 0.125 | 4.6 |
| JLCC 30890 | 8 | 0.031 | 6.5 |
| JLCC 31354 | 8 | 0.031 | 5.0 |
| JLCC 31473 | 8 | 0.031 | 8.0 |
| JLCC 31495 | 4 | 0.031 | 8.0 |
| JLCC 31631 | 8 | 0.031 | 5.7 |
| JLCC 31584 | 8 | 0.031 | 8.0 |
| JLCC 31658 | 8 | 0.031 | 7.0 |
| JLCC 31660 | 4 | 0.031 | 6.0 |
| JLCC 31661 | 8 | 0.031 | 5.1 |
| JLCC 31671 | 8 | 0.031 | 4.4 |
| JLCC 31683 | 8 | 0.031 | 4.5 |
| JLCC 31699 | 32 | 0.125 | 4.0 |
| JLCC 31715 | 8 | 0.031 | 4.9 |
| JLCC 32069 | 16 | 0.063 | 4.4 |
| JLCC 32071 | 256 | 0.250 | 3.7 |
| JLCC 32712 | 8 | 0.031 | 3.9 |
| JLCC 33802 | 8 | 0.031 | 6.6 |
| JLCC 33803 | 4 | 0.031 | 8.0 |
| Giant colonies | Diameter (cm) | |||
|---|---|---|---|---|
| 3 d | 5 d | 7 d | 10 d | |
| A. fumigatus alone | 1.19 ± 0.09 | 4.29 ± 0.11 | 6.99 ± 0.13 | 9.00 ± 0.10 |
| A. fumigatus treated with BER | 0.04 ± 0.07 | 1.50 ± 0.08 | 3.92 ± 0.09 | 7.10 ± 0.09 |

2.1.2. Fractional Inhibitory Concentration Index
2.1.3. Assessment of Ergosterol Content

2.1.4. Real-Time PCR

2.2. Discussion
3. Experimental Section
3.1. Strains, Media and Conditions
3.2. Antifungal Drug Susceptibility Testing
3.3. Strain Culture
3.4. Fractional Inhibitory Concentration Index
3.5. Assessment of Ergosterol Content
3.5.1. Total Ergosterol Extraction
3.5.2. HPLC Analysis
3.6. Real-Time PCR
| Locus tag | Protein description | Primer sequence (5′-3′) | Size of PCR product (bp) |
|---|---|---|---|
| AFUA_1G04720(Erg1) | C-8 sterol isomerase | F: TGCGATGGTCGACTTCATTGT | 105 |
| R: ACCCATAGCACCACCAGCATT | |||
| AFUA_5G07780(Erg1) | Squalenemonooxygenase Erg1 | F: ATTGACAGGAGGCGGAATGAC | 112 |
| R: GCTGCTTCATGACTCGCTTTG | |||
| AFUA_6G05140(Erg3) | Sterol delta 5,6-desaturase | F: AAGCCGTTTGTGTACGAACCC | 113 |
| R: AAAGAAGCTCAGGAACTGGCG | |||
| AFUA_1G03950(Erg5) | Cytochrome P450 sterol C-22 | F: TCAATTCGCCAGCTTACGTCA | 101 |
| desaturase | R: ATTCAACGTGCTCCTTGCCA | ||
| AFUA_4G03630(Erg6) | Sterol 24-c-methyltransferase | F: CGGATCGTTCAAGCACATGAC | 107 |
| R: TTTCCATAGCTCCGCAGAACC | |||
| AFUA_4G06890(Erg11) | 14-alpha sterol demethylase Cyp51A | F: TGCGCACATGATGATAACCC | 101 |
| R: TCGAGGACTTTTGGCTGTGAG | |||
| AFUA_7G03740(Erg11) | 14-alpha sterol demethylase Cyp51B | F: AAAATTCTCCGGCGTTCCAG | 100 |
| R: TTTTCCTTGAAGCGAGCGC | |||
| AFUA_1G03150(Erg24) | C-14sterol reductase | F:CGATTGGCTGATGTCATGGTC | 102 |
| R:TATGGCCTGCTTCTGCATGTC | |||
| AFUA_4G04820(Erg25) | C-4 methyl sterol oxidase Erg25 | F:GCCGAATATGCATCGCCTATT | 102 |
| R:TCGTGAAGATATGCAGGTCGC | |||
| AFUA_8G02440(Erg25) | C-4 methyl sterol oxidase | F:AGGCGGATTTTGCCGTTCT | 115 |
| R:GCAACCGTACCCATCAACACA | |||
| AFUA_2G15030(Erg26) | C-3 sterol dehydrogenase/C-4 decarboxylase | F: AAGCATCCCCGACCGTTTT | 112 |
| R: AAGAAGACGGTATGCGGCAAG | |||
| AFUA_2G17400(Erg26) | C-3 sterol dehydrogenase/C-4 decarboxylase family protein | F:GGTGCAGATTGGCAACAACAA | 102 |
| R: ATTTTGGCATGTAACCAGCGC | |||
| AFUA_4G11500(Erg27) | 3-keto steroid reductase | F:ACGAGTCACCTTTGTGGCTGA | 105 |
| R:CACGATCGCATCGAGTTTAGG | |||
| AFUA_2G11500(Erg28) | Ergosterol biosynthesis protein Erg28 | F:CTGCCCAAATGGCTCGTCT | 104 |
| R:TGGAGGCTGTTGATTGCAGAG | |||
| AFUA_1G14550(MnSOD) | Mn superoxide dismutase | F: CCTACGTCAATGGCCTGAATG | 100 |
| R: GAATTTGATCGCTTGCTGCA | |||
| AFUA_6G07820(IMP) | Integral membrane protein | F: TGCATTTACCACATTGGCCA | 105 |
| R: CAGAGCCACAATGATAGCCCA | |||
| AFUA_5G01030(GAPDH) | Glyceraldehyde3-phosphate dehydrogenase | F: TCGCTGAATGCCAATTTCGT | 106 |
| R: AGCATCGACACTGGCGATATG |
3.7. Statistical Analysis
4. Conclusions
Acknowledgments
References and Notes
- Gersuk, G.M.; Underhill, D.M.; Zhu, L.; Marr, K.A. Dectin-1 and TLRs permit macrophages to distinguish between different Aspergillus fumigatus cellular states. J. Immunol. 2006, 176, 3717–3724. [Google Scholar]
- Gavalda, J.; Roman, A. Infection in lung transplantation. Enferm. Infecc. Microbiol. Clin. 2007, 25, 639–649, quiz 650. [Google Scholar] [CrossRef]
- Aydogan, S.; Kustimur, S.; Kalkanci, A. Comparison of glucan and galactomannan tests with real-time PCR for diagnosis of invasive aspergillosis in a neutropenic rat model. Mikrobiyol. Bul. 2010, 44, 441–452. [Google Scholar]
- Iwazaki, R.S.; Endo, E.H.; Ueda-Nakamura, T.; Nakamura, C.V.; Garcia, L.B.; Filho, B.P. In vitro antifungal activity of the berberine and its synergism with fluconazole. Antonie Van Leeuwenhoek 2009, 97, 201–205. [Google Scholar]
- Limper, A.H.; Knox, K.S.; Sarosi, G.A.; Ampel, N.M.; Bennett, J.E.; Catanzaro, A.; Davies, S.F.; Dismukes, W.E.; Hage, C.A.; Marr, K.A.; et al. An official American thoracic society statement: Treatment of fungal infections in adult pulmonary and critical care patients. Am. J. Respir. Crit. Care. Med. 2011, 183, 96–128. [Google Scholar] [CrossRef]
- Billaud, E.M.; Guillemain, R.; Berge, M.; Amrein, C.; Lefeuvre, S.; Louet, A.L.; Boussaud, V.; Chevalier, P. Pharmacological considerations for azole antifungal drug management in cystic fibrosis lung transplant patients. Med. Mycol. 2010, 48 (Suppl. 1), S52–S59. [Google Scholar] [CrossRef]
- Kulkarni, S.K.; Dhir, A. Berberine: A plant alkaloid with therapeutic potential for central nervous system disorders. Phytother. Res. 2009, 24, 317–324. [Google Scholar] [CrossRef]
- Cordero, C.P.; Gomez-Gonzalez, S.; Leon-Acosta, C.J.; Morantes-Medina, S.J.; Aristizabal, F.A. Cytotoxic activity of five compounds isolated from Colombian plants. Fitoterapia 2004, 75, 225–227. [Google Scholar] [CrossRef]
- Hawrelak, J. Giardiasis: Pathophysiology and management. Altern. Med. Rev. 2003, 8, 129–142. [Google Scholar]
- Cecil, C.E.; Davis, J.M.; Cech, N.B.; Laster, S.M. Inhibition of H1N1 influenza A virus growth and induction of inflammatory mediators by the isoquinoline alkaloid berberine and extracts of goldenseal (Hydrastis canadensis). Int. Immunopharmacol. 2011. [Epub ahead of print]. [Google Scholar]
- Kim, J.H.; Campbell, B.C.; Mahoney, N.; Chan, K.L.; Molyneux, R.J.; May, G.S. Enhanced activity of strobilurin and fludioxonil by using berberine and phenolic compounds to target fungal antioxidative stress response. Lett. Appl. Microbiol. 2007, 45, 134–141. [Google Scholar] [CrossRef]
- Park, K.D.; Cho, S.J.; Moon, J.S.; Kim, S.U. Synthesis and antifungal activity of a novel series of 13-(4-isopropylbenzyl)berberine derivatives. Bioorg. Med. Chem. Lett. 2010, 20, 6551–6554. [Google Scholar] [CrossRef]
- Park, K.D.; Lee, J.H.; Kim, S.H.; Kang, T.H.; Moon, J.S.; Kim, S.U. Synthesis of 13-(substituted benzyl) berberine and berberrubine derivatives as antifungal agents. Bioorg. Med. Chem. Lett. 2006, 16, 3913–3916. [Google Scholar]
- Xu, Y.; Wang, Y.; Yan, L.; Liang, R.M.; Dai, B.D.; Tang, R.J.; Gao, P.H.; Jiang, Y.Y. Proteomic analysis reveals a synergistic mechanism of fluconazole and berberine against fluconazole- resistant Candida albicans: Endogenous ROS augmentation. J. ProteomeRes. 2009, 8, 5296–5304. [Google Scholar]
- Freile, M.L.; Giannini, F.; Pucci, G.; Sturniolo, A.; Rodero, L.; Pucci, O.; Balzareti, V.; Enriz, R.D. Antimicrobial activity of aqueous extracts and of berberine isolated from Berberis heterophylla. Fitoterapia 2003, 74, 702–705. [Google Scholar] [CrossRef]
- Nakamoto, K.; Tamamoto, M.; Hamada, T. In vitro study on the effects of trial denture cleansers with berberine hydrochloride. J. Prosthet. Dent. 1995, 73, 530–533. [Google Scholar] [CrossRef]
- Soffar, S.A.; Metwali, D.M.; Abdel-Aziz, S.S.; El-Wakil, H.S.; Saad, G.A. Evaluation of the effect of a plant alkaloid (berberine derived from Berberis aristata) on Trichomonas vaginalis in vitro. J. Egypt Soc. Parasitol. 2001, 31, 893–904, + 1p plate. [Google Scholar]
- Sun, D.; Courtney, H.S.; Beachey, E.H. Berberine sulfate blocks adherence of Streptococcus pyogenes to epithelial cells, fibronectin, and hexadecane. Antimicrob. Agents Chemother. 1988, 32, 1370–1374. [Google Scholar] [CrossRef]
- Bian, X.; He, L.; Yang, G. Synthesis and antihyperglycemic evaluation of various protoberberine derivatives. Bioorg. Med. Chem. Lett. 2006, 16, 1380–1383. [Google Scholar] [CrossRef]
- Park, K.S.; Kang, K.C.; Kim, K.Y.; Jeong, P.Y.; Kim, J.H.; Adams, D.J.; Paik, Y.K. HWY-289, a novel semi-synthetic protoberberine derivative with multiple target sites in Candida albicans. J. Antimicrob. Chemother. 2001, 47, 513–519. [Google Scholar] [CrossRef]
- Park, K.S.; Kang, K.C.; Kim, J.H.; Adams, D.J.; Johng, T.N.; Paik, Y.K. Differential inhibitory effects of protoberberines on sterol and chitin biosyntheses in Candida albicans. J. Antimicrob. Chemother. 1999, 43, 667–674. [Google Scholar] [CrossRef]
- Xu, M.G.; Wang, J.M.; Chen, L.; Wang, Y.; Yang, Z.; Tao, J. Berberine-induced upregulation of circulating endothelial progenitor cells is related to nitric oxide production in healthy subjects. Cardiology 2009, 112, 279–286. [Google Scholar] [CrossRef]
- Liu, Z.; Liu, Q.; Xu, B.; Wu, J.; Guo, C.; Zhu, F.; Yang, Q.; Gao, G.; Gong, Y.; Shao, C. Berberine induces p53-dependent cell cycle arrest and apoptosis of human osteosarcoma cells by inflicting DNA damage. Mutat. Res. 2009, 662, 75–83. [Google Scholar] [CrossRef]
- Holy, E.W.; Akhmedov, A.; Luscher, T.F.; Tanner, F.C. Berberine, a natural lipid-lowering drug, exerts prothrombotic effects on vascular cells. J. Mol. Cell. Cardiol. 2009, 46, 234–240. [Google Scholar] [CrossRef] [Green Version]
- Zhang, W.; Xu, Y.C.; Guo, F.J.; Meng, Y.; Li, M.L. Anti-diabetic effects of cinnamaldehyde and berberine and their impacts on retinol-binding protein 4 expression in rats with type 2 diabetes mellitus. Chin. Med. J. (Engl.) 2008, 121, 2124–2128. [Google Scholar]
- Wang, Y.; Campbell, T.; Perry, B.; Beaurepaire, C.; Qin, L. Hypoglycemic and insulin-sensitizing effects of berberine in high-fat diet- and streptozotocin-induced diabetic rats. Metabolism 2010, 60, 298–305. [Google Scholar]
- Wang, Z.S.; Lu, F.E.; Xu, L.J.; Dong, H. Berberine reduces endoplasmic reticulum stress and improves insulin signal transduction in Hep G2 cells. ActaPharmacol. Sin. 2010, 31, 578–584. [Google Scholar]
- Wu, N.; Sarna, L.K.; Siow, Y.L.; Karmin, O. Regulation of hepatic cholesterol biosynthesis by berberine during hyperhomocysteinemia. Am. J. Physiol. Regul. Integr. Comp. Physiol. 2010, 300, R635–R643. [Google Scholar]
- Quan, H.; Cao, Y.Y.; Xu, Z.; Zhao, J.X.; Gao, P.H.; Qin, X.F.; Jiang, Y.Y. Potent in vitro synergism of fluconazole and berberine chloride against clinical isolates of Candida albicans resistant to fluconazole. Antimicrob. AgentsChemother. 2006, 50, 1096–1099. [Google Scholar] [CrossRef]
- Han, Y.; Lee, J.H. Berberine synergy with amphotericin B against disseminated candidiasis in mice. Biol. Pharm. Bull. 2005, 28, 541–544. [Google Scholar] [CrossRef]
- Klepser, M.E. New insights in medical mycology: Focus on fungal infections. Introduction. Pharmacotherapy 2001, 21, 109–110. [Google Scholar] [CrossRef]
- Carroll, P.M.; Dougherty, B.; Ross-Macdonald, P.; Browman, K.; FitzGerald, K. Model systems in drug discovery: Chemical genetics meets genomics. Pharmacol. Ther. 2003, 99, 183–220. [Google Scholar] [CrossRef]
- Bien, C.M.; Chang, Y.C.; Nes, W.D.; Kwon-Chung, K.J.; Espenshade, P.J. Cryptococcus neoformans site-2 protease is required for virulence and survival in the presence of azole drugs. Mol. Microbiol. 2009, 74, 672–690. [Google Scholar] [CrossRef]
- Ouyang, H.M.; Luo, Y.M.; Zhang, L.; Li, Y.J.; Jin, C. Proteome analysis of Aspergillus fumigatus total membrane proteins identifies proteins associated with the glycoconjugates and cell wall biosynthesis using 2D LC-MS/MS. Mol. Biotechnol. 2010, 44, 177–189. [Google Scholar] [CrossRef]
- Cornell, M.J.; Alam, I.; Soanes, D.M.; Wong, H.M.; Hedeler, C.; Paton, N.W.; Rattray, M.; Hubbard, S.J.; Talbot, N.J.; Oliver, S.G. Comparative genome analysis across a kingdom of eukaryotic organisms: specialization and diversification in the fungi. GenomeRes. 2007, 17, 1809–1822. [Google Scholar]
- Wang, L.; Yokoyama, K.; Miyaji, M.; Nishimura, K. The identification and phylogenetic relationship of pathogenic species of Aspergillus based on the mitochondrial cytochrome b gene. Med. Mycol. 1998, 36, 153–164. [Google Scholar]
- Espinel-Ingroff, A.; Fothergill, A.; Fuller, J.; Johnson, E.; Pelaez, T.; Turnidge, J. Wild-type MIC distributions and epidemiological cutoff values for caspofungin and Aspergillus spp. for the CLSI broth microdilution method (M38-A2 document). Antimicrob. Agents Chemother. 2011, 55, 2855–2859. [Google Scholar] [CrossRef]
- Kim, J.H.; Campbell, B.C.; Mahoney, N.; Chan, K.L.; Molyneux, R.J.; May, G.S. Enhanced activity of strobilurin and fludioxonil by using berberine and phenolic compounds to target fungal antioxidative stress response. Lett. Appl. Microbiol. 2007, 45, 134–141. [Google Scholar] [CrossRef]
- Qiu, W.Y.; Yao, Y.F.; Zhu, Y.F.; Zhang, Y.M.; Zhou, P.; Jin, Y.Q.; Zhang, B. Fungal spectrum identified by a new slide culture and in vitro drug susceptibility using Etest in fungal keratitis. Curr. EyeRes. 2005, 30, 1113–1120. [Google Scholar]
- Rand, K.H.; Houck, H.J.; Brown, P.; Bennett, D. Reproducibility of the microdilution checkerboard method for antibiotic synergy. Antimicrob. Agents Chemother. 1993, 37, 613–615. [Google Scholar] [CrossRef]
- Odds, F.C. Synergy, antagonism, and what the chequerboard puts between them. J. Antimicrob. Chemother. 2003, 52, 1. [Google Scholar] [CrossRef]
- Alcazar-Fuoli, L.; Mellado, E.; Garcia-Effron, G.; Lopez, J.F.; Grimalt, J.O.; Cuenca-Estrella, J.M.; Rodriguez-Tudela, J.L. Ergosterol biosynthesis pathway in Aspergillus fumigatus. Steroids 2008, 73, 339–347. [Google Scholar] [CrossRef]
- Nicot, N.; Hausman, J.F.; Hoffmann, L.; Evers, D. Housekeeping gene selection for real-time RT-PCR normalization in potato during biotic and abiotic stress. J. Exp. Bot. 2005, 56, 2907–2914. [Google Scholar] [CrossRef]
- Schmittgen, T.D.; Livak, K.J. Analyzing real-time PCR data by the comparative C(T) method. Nat. Protoc. 2008, 3, 1101–1108. [Google Scholar] [CrossRef]
- Tseng, C.P.; Cheng, A.J.; Chang, J.T.; Tseng, C.H.; Wang, H.M.; Liao, C.T.; Chen, I.H.; Tseng, K.C. Quantitative analysis of multidrug-resistance mdr1 gene expression in head and neck cancer by real-time RT-PCR. Jpn.J. CancerRes. 2002, 93, 1230–1236. [Google Scholar] [CrossRef]
- Livak, K.J.; Schmittgen, T.D. Analysis of relative gene expression data using real-time quantitative PCR and the 2(-Delta Delta C(T)) Method. Methods 2001, 25, 402–408. [Google Scholar] [CrossRef]
- Sample Availability: Samples of the compounds BER and ICZ are available from the authors.
© 2011 by the authors; licensee MDPI, Basel, Switzerland. This article is an open access article distributed under the terms and conditions of the Creative Commons Attribution license ( http://creativecommons.org/licenses/by/3.0/).
Share and Cite
Lei, G.; Dan, H.; Jinhua, L.; Wei, Y.; Song, G.; Li, W. Berberine and Itraconazole Are not Synergistic in Vitro against Aspergillus fumigatus Isolated from Clinical Patients. Molecules 2011, 16, 9218-9233. https://doi.org/10.3390/molecules16119218
Lei G, Dan H, Jinhua L, Wei Y, Song G, Li W. Berberine and Itraconazole Are not Synergistic in Vitro against Aspergillus fumigatus Isolated from Clinical Patients. Molecules. 2011; 16(11):9218-9233. https://doi.org/10.3390/molecules16119218
Chicago/Turabian StyleLei, Gao, He Dan, Liu Jinhua, Yan Wei, Gao Song, and Wang Li. 2011. "Berberine and Itraconazole Are not Synergistic in Vitro against Aspergillus fumigatus Isolated from Clinical Patients" Molecules 16, no. 11: 9218-9233. https://doi.org/10.3390/molecules16119218




